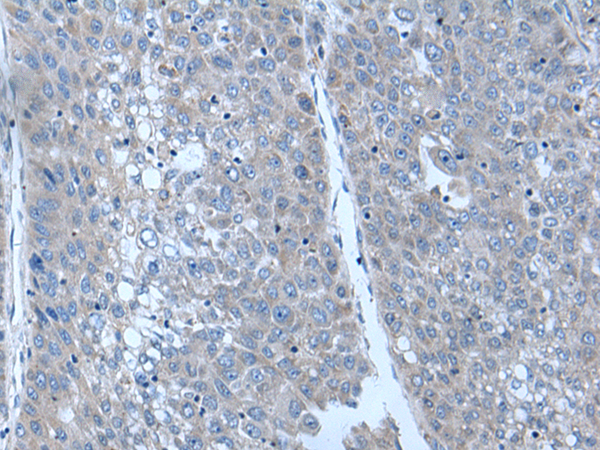

-
分类: 科研抗体货号: P12294别名: HLS5; MAIR应用: WB,IHC反应种属: Human
-
分类: 科研抗体货号: P12273别名: TBC; TBC1应用: IHC反应种属: Human
-
分类: 科研抗体货号: P12314别名: TOPIIB; top2beta应用: WB反应种属: Human, Mouse
-
分类: 科研抗体货号: P12293别名: EFP; Z147; RNF147; ZNF147应用: IHC反应种属: Human
-
分类: 科研抗体货号: P12270别名: TLN; ILWEQ应用: WB,IHC反应种属: Human, Mouse
-
分类: 科研抗体货号: P12313别名: TEM; CHM1L; BRICD4应用: WB,IHC反应种属: Human, Mouse, Rat
-
分类: 科研抗体货号: P12291别名: ARD1; ARFD1; RNF46应用: IHC反应种属: Human, Mouse, Rat
-
分类: 科研抗体货号: P12268别名: Npl3; RBP56; TAF2N; TAFII68应用: WB,IHC反应种属: Human
-
分类: 科研抗体货号: P12312别名: VAN; NAF1; ABIN-1; nip40-1应用: WB,IHC反应种属: Human, Mouse
-
分类: 科研抗体货号: P12288别名: ECTO; PTC7; RFG7; TF1G; TIF1G; TIFGAMMA; TIF1GAMMA应用: IHC反应种属: Human, Mouse

鄂公网安备42018502007531号
鄂公网安备42018502007531号

